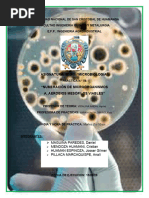

Antibiograma
Introduccin
Se entiende por antibiograma el estudio de la sensibilidad "in vitro" de
las
bacterias
los
antibiticos,
aunque
se
extiende
algunos
quimioterpeuticos. El antibiograma es un mtodo de diagnstico rpido y
preciso, ya que no se puede predecir la susceptibilidad de las bacterias,
hongos y virus a los agentes antimicrobianos, con frecuencia es necesario
estudiar la sensibilidad individual de cada patgeno a estas drogas, pudindose
elegir entonces el agente apropiado que provee mayores posibilidades de una
evolucin favorable.
Objetivos
1. Determinar la sensibilidad a diversos antibiticos de un determinado
microorganismo.
2. Comprender el concepto de antibitico y su especificidad de accin
sobre determinadas bacterias.
3. Conocer el concepto de cepa sensible y resistente.
4. Entender el concepto de halo de inhibicin.
5. Ser consciente de la importancia de la higiene y el cuidado en la
manipulacin de materiales biolgicos.
6. Comprender la importancia de la eliminacin de los residuos orgnicos.
7. Conocer el instrumental de laboratorio necesario en microbiologa y los
procedimientos para su utilizacin.
Metodologa
Preparacin de medios de cultivo y siembra de bacterias en medios de cultivo.
Esterilizacin. Con esta prctica se pretende aprender las tcnicas de
preparacin de diferentes medios de cultivo, su esterilizacin y su almacenaje,
as como la importancia de los diferentes medios de cultivo y su uso. Adems
tambin se pretende que el alumno se familiarice con las tcnicas empleadas
en Microbiologa para el cultivo y la manipulacin de microorganismos en
condiciones de esterilidad.
�Transformacin bacteriana por resistencia a
ampicilinas.
En esta prctica se hablar de los fenmenos de transformacin, conjugacin y
transduccin y se realizar un ensayo de transformacin bacteriana por
adquisicin de plsmidos resistentes al antibitico ampicilina.
Antibiograma.
El objetivo de esta prctica es estudiar qu son los antibiticos y cmo se
realiza la valoracin de la actividad antimicrobiana de un compuesto qumico
(antibitico).
Tincin de cpsula.
En esta prctica se estudiarn las cpsulas bacterianas y se proceder a una
tincin diferencial para la visualizacin de la misma al microscopio.
Preparacin de medios y siembra de bacterias en
medios de cultivo
Fundamento:
Un medio de cultivo es un conjunto de nutrientes, factores de crecimiento y
otros componentes que crean las condiciones necesarias para el desarrollo de
los
microorganismos.
Puesto
que
la
diversidad
metablica
de
los
microorganismos es enorme, la variedad de medios de cultivo es tambin muy
grande. La mayora de los medios de cultivo se comercializan en forma de
liofilizados que es preciso rehidratar. La preparacin de un medio de cultivo se
reduce en general a pesar la cantidad de medio y redisolverla en agua
siguiendo las instrucciones del fabricante. Las sustancias termolbiles se
esterilizan por filtracin y se aaden al resto de los componentes previamente
esterilizados en la autoclave. Los constituyentes habituales de los medios de
cultivo son:
1. Agar. Se utiliza como agente solidificante. Es un polisacrido que se obtiene
de ciertas algas marinas. Las bacterias no son capaces de degradarlo.
2. Azcares. Son una fuente de carbono para los microorganismos. Los ms
empleados son la glucosa, la lactosa y la sacarosa.
�3. Extractos. Son preparados de ciertos rganos o tejidos animales o vegetales
obtenidos con agua y calor. Ej.: extracto de carne, de levadura, de malta, etc.
4. Peptonas. Son protenas hidrolizadas, se obtienen por digestin qumica o
enzimtica de protenas animales o vegetales.
5. Fluidos corporales. Sangre completa, sangre desfibrinada, plasma o suero
sanguneo son aadidos a los medios empleados para el cultivo de algunos
microorganismos patgenos.
Tipos de medios de cultivo.
Por su consistencia:
a) Slidos. Son aquellos que contienen un agente solidificante entre sus
Componentes, normalmente agar. Se preparan en placas de Petri o en tubos
en slant(tubos con la superficie del medio inclinada).
Siembra de microorganismos
En trminos microbiolgicos se entiende por siembra el proceso mediante el
cual se lleva una porcin de una poblacin de microorganismos de un cultivo
bacteriano a un medio nutritivo para su crecimiento.
Realizacin de siembra:
1) Que se lleve a cabo con instrumentos estriles sobre medios de cultivo
estriles. Para estudiar una bacteria determinada, es necesario destruir todos
aquellos microorganismos que pudieran encontrarse en el medio y en los
instrumentos de trabajo. Esto se consigue con la ESTERILIZACION, proceso
que consiste en conseguir que todos los microorganismos presentes mueran
desde el punto de vista microbiolgico.
La esterilizacin
Se utilizan dos tipos principales de esterilizacin:
Por MTODOS FSICOS (calor).
�Los medios de cultivo se esterilizan en el AUTOCLAVE, el cual hace uso del
calor hmedo. La autoclave es un aparato que permite elevar la presin y la
temperatura con lo que se consigue un aumento en la temperatura de ebullicin
del agua. Normalmente, se lleva la presin a 1 atmsfera (por encima de la
ambiental) lo que corresponde a una temperatura interior de 126C,
mantenindolo en estas condiciones durante 20 minutos. Todo el material de
vidrio (pipetas, tubos, varillas.etc.) se esteriliza con calor seco, se somete a
temperaturas de 140-180 C durante 2h-3h. En el caso de objetos metlicos,
como el asa de siembra, que se esterilizan en el momento de su utilizacin, se
mantienen en la llama hasta que se pongan al rojo, teniendo la precaucin de
enfriarlos antes de su uso.
2) Que el inculo no se contamine, modifique o destruya: Normalmente se
emplea el calor directo, flameando las bocas de los tubos de ensayo, matraces,
pipeta, etc. antes y despus de su utilizacin, a pesar de estar esterilizados
previamente.
3) Que las condiciones ambientales durante el proceso sean lo ms prximas a
la esterilidad para evitar contaminaciones durante el manejo del instrumental y
de los medios de cultivo, se utiliza un mechero Bunsen debido a que fuerza la
circulacin del aire en sentido vertical y hacia arriba, es capaz de crear un
ambiente semiestril en la zona inmediata alrededor y debajo de la llama, de
forma que los riesgos de contaminacin disminuyen considerablemente.
Material de la Prctica:
Mechero bunsen o similar
Asa de siembra
Tubos con cultivos bacterianos crecidos
Obtencin de cultivos puros
Introduccin
Un cultivo puro es aquel que contiene una sola clase de microorganismos. Para
obtenerlo es necesario recurrir a las llamadas tcnicas de aislamiento. Aunque
�existen otras, las tcnicas ms utilizadas emplean un medio de cultivo slido,
en el que los microorganismos generan colonias separadas. Se puede
demostrar que cada colonia procede de una sola clula o de un grupo de
clulas del mismo tipo si el microorganismo forma agregados. Por ello lo ms
correcto es hablar de unidades formadoras de colonias (UFC) al referirnos al
origen de una colonia. Por tanto, todas las bacterias de una colonia son
genticamente iguales y constituyen un clon.
En esta prctica emplearemos dos mtodos para obtener un cultivo puro:
Aislamiento por agotamiento por estras
Aislamiento por siembra de diluciones seriadas
Agotamiento por estras.
Se trata de un mtodo rpido y simple de agotamiento progresivo y continuo
del inculo sobre un medio slido contenido en una placa de Petri. El objetivo
es obtener, a partir de un elevado nmero de bacterias, un nmero reducido de
ellas distribuidas individualmente sobre la superficie de la placa. Cada una de
estas bacterias originar una colonia.
Procedimiento:
1. Esterilizar el asa y enfriarla en las proximidades del mechero.
2. Tomar el inculo como se ha descrito anteriormente.
3. Transferir el inculo a un ara pequea de la superficie de la placa, prxima
al borde. Extenderlo formando estras muy juntas sobre la superficie de una
porcin pequea de la placa.
4. Flamear el asa y enfriarla. Rozar una vez con el asa las estrias sembradas la
Primera vez y realizar sobre una porcin virgen de la placa una segunda tanda
de estras que no toque la primera.
5. Flamear y enfriar el asa. Repetir la operacin descrita en el apartado
anterior, pero rozando al empezar la segunda tanda de estrias.
6. Flamear el asa y cerrar la placa e incubar a 37C.
�Observacin de bacterias teidas
Para observar las bacterias teidas es necesario, en primer lugar, hacer un
frotis de las bacterias y fijarlo. Para hacer un frotis, cuando se parte de un
cultivo de bacterias en medio lquido, se toma una o varias cargas directamente
con el asa y se extienden sobre el portaobjetos. Si se parte de un cultivo en
medio slido, debe depositarse previamente una gota de agua sobre el
portaobjetos. A continuacin, se toma con el asa una pequea parte de la
colonia y se dispersa en la gota de agua, realizndose la extensin como en el
caso anterior. La fijacin tiene por objeto provocar modificaciones en la
composicin fsico-qumica de la bacteria (coagulacin de las protenas, etc.)
de forma que sta conserve definitivamente una estructura similar a la que
tena en vivo, sin deformarse como consecuencia de los tratamientos a que se
ver sometida durante la tincin. Por otra parte la fijacin impide el arrastre de
los microorganismos al quedar estos adheridos al portaobjetos y hace que la
pared celular sea ms permeable a los colorantes. Para la fijacin pueden
utilizarse agentes qumicos (formol, metanol) o el calor. Nosotros emplearemos
el calor, y para ello el frotis, una vez seco, se pasa dos o tres veces sobre la
llama, con la preparacin hacia arriba, para no quemarla. Hay que procurar que
el calor nunca sea excesivo, pues se alteraran las estructuras de la bacteria:
en ningn momento el portaobjetos, colocado sobre el dorso de la mano, debe
quemar.
Material:
Portaobjetos.
Mechero Bunsen.
Asa de siembra.
Tubos con cultivos de bacterias Gram-positivas y Gram-negativas.
Cubetas de tincin o similar.
Colorantes para las tinciones: Cristal violeta, Lugol, Alcohol-Acetona (1:1) y
Safranina.
Mtodo:
�1) Realizacin del frotis y la fijacin de los diferentes cultivos de bacterias. Se
proceder tal y como se ha descrito anteriormente.
2) Tinciones:
A) La tincin simple es la tincin en que se utiliza un solo colorante.
Como colorantes utilizaremos el azul de metileno o la safranina, ambos de
naturaleza bsica. La tcnica es la siguiente:
1. Hacer el frotis, secarlo y fijarlo.
2. Cubrir con colorante la preparacin y dejarlo actuar durante un minuto.
3. Lavar suavemente con agua destilada para eliminar el exceso de colorante.
4. Secar al aire y observar al microscopio con el objetivo de inmersin (100x)
empleando el aceite apropiado.
Esta tcnica permite observar la morfologa y tamao de las bacterias, as
como los tipos de agrupaciones que forman.
B) La TINCIN DE GRAM es la tincin diferencial ms utilizada en
Bacteriologa pues permite separar las bacterias en dos grandes grupos, las
Grampositivas y las Gram-negativas. La tincin de Gram requiere cuatro
soluciones:
1. Primer colorante. Es un colorante bsico que en contacto con las clulas
cargadas negativamente, reacciona con ellas colorendolas. El ms utilizado
es el cristal violeta.
2. Solucin mordiente. Fija las tinciones y aumenta la afinidad entre el colorante
y las clulas. Los mordientes empleados suelen ser sales metlicas, cidos o
bases, como, por ejemplo, una solucin diluida de yodo.
3. Agente decolorante. Es un disolvente orgnico.
4. Colorante de contraste. Es un colorante bsico de distinto color que el primer
colorante, como, por ejemplo, la safranina. Los dos grupos bacterianos a los
que anteriormente nos referamos difieren en el color conel que finalmente
aparecen. Las bacterias Gram positivas se teirn de azul por el cristal violeta y
no perdern esta coloracin durante los pasos sucesivos. Las bacterias Gram
negativas perdern la coloracin inicial del cristal violeta en los siguientes
pasos y se teirn de rosa debido a la safranina. La diferencia est
determinada por la composicin de su envoltura celular. Las bacterias gram
positivas poseen una malla de peptidoglicano en su parte ms externa,
�mientras que las bacterias gram negativas, recubriendo una fina capa de
peptidoglicano, presentan una membrana externa que envuelve toda la clula.
El mtodo de tincin es el siguiente:
1. Se prepara el frotis, se seca y se fija.
2. Se cubre con cristal violeta durante un minuto.
3. Lavar suavemente con agua destilada para eliminar el exceso de colorante.
4. Se traza con lugol un minuto. El lugol acta como mordiente aumentando la
afinidad del colorante por la bacteria.
5. Lavar con agua el exceso de lugol.
6. Se gotea alcohol-acetona de forma continua hasta que la preparacin deje
de perder color y se lava enseguida con agua abundante.
7. Se cubre la preparacin con un colorante de contraste, como la safranina,
durante un minuto.
8. Se lava con agua y se seca al aire, observndose a continuacin con el
objetivo de inmersin.
3) Observacin de las tinciones de bacterias al microscopio.
Las bacterias Gram-positivas presentarn una coloracin violeta mientras que
las Gram-negativas la presentarn roja o rosa. La identificacin de las bacterias
Gram-positivas puede ser problemtica, solamente cuando las bacterias
Grampositivas se encuentran en crecimiento exponencial (cultivos jvenes) la
reaccin es clara; en fase estacionaria (cultivos viejos) las bacterias Grampositivas pueden parecer Gram-negativas.
Antibiograma
Introduccin
En nuestros das han sido puestos a nuestra disposicin para la lucha contra
las enfermedades bacterianas gran cantidad de agentes antibacterianos.
Los antibiticos son sustancias qumicas producidas por microorganismos o
derivados semisintticos de stas, mientras que los quimioterpicos son
�productos de sntesis qumica, pero ambos tienen la propiedad de estar
dotados de actividad antibacteriana. Todas las bacterias no tienen la misma
sensibilidad a los distintos antibacterianos. La evaluacin de esta sensibilidad
nos va a ayudar en la seleccin del compuesto ms adecuado para el
tratamiento de una infeccin bacteriana. Las pruebas ms utilizadas para
evaluar la sensibilidad de una bacteria a un agente antibacteriano estn
basadas en el enfrentamiento in vitro de la bacteria con distintas
concentraciones del agente.
Fundamento
El antibiograma por el mtodo de difusin en agar es una prueba en la que se
enfrenta la bacteria inoculada sobre la superficie de un medio de agar con una
solucin antibitica absorbida en discos de papel de filtro. Este mtodo est
estandarizado y los halos de inhibicin han sido obtenidos correlacionndolos
con las CMI y aparecen en unas tablas. Hay varios factores que afectan al halo
de inhibicin: la carga del antibitico en los discos, la difusin del antibitico en
el medio de cultivo, el tamao del inculo bacteriano, la composicin y grosor
del medio de cultivo, la velocidad del crecimiento bacteriano y el tiempo de
incubacin. Los discos de antibiticos son adquiridos comercialmente. Deben
contener la cantidad establecida de antibitico y ser conservados a 4C
protegidos de la humedad.
Objetivos
Determinar la sensibilidad bacteriana a distintos antibiticos utilizando una
metodologa sencilla y asequible a cualquier laboratorio de Microbiologa.
Material necesario
- Cultivo puro de Staphylococcus aureus y Escherichia coli.
- Placas de LB agar.
- Discos comerciales de antibiticos.
- Hisopos estriles
�- Pinzas de laboratorio.
Realizacin
1. Preparacin del inculo. Partiendo de un cultivo puro tomar con el asa de
siembra X colonias de la bacteria e introducirlas en el caldo de cultivo.
2. Inocular la superficie de una placa de agar con el hisopo pasndolo
uniformemente por toda la superficie en tres direcciones. Por ltimo, pasar el
hisopo por el reborde de la placa de agar. Dejar secar 5 minutos. Colocar los
discos de antibiticos sobre la superficie del agar utilizando unas pinzas
estriles y apretndolos suavemente sobre la superficie del agar. Los discos no
deben estar a menos de 15 mm de los bordes de la placa y lo bastante
separados entre ellos para que no se superpongan sus zonas de inhibicin.
Dejar las placas 15 minutos a temperatura ambiente para que comiencen a
difundir los antibiticos.
3. Incubar la placa en posicin invertida a 37C durante 18-24 horas.
�estudio
1- siembra
Coprocultivo
Agar Sangre
Mc conkey
Siembra de muestras y exmenes de laboratorio
Crecimiento
Pruebas
resultados
bioqumicas
Agar sangre
Colonias
TSI
Produccin de gas
pequeas y
Produccin de H2S
blancas
LIA
Descarboxilacion de
lisina
Descarminacion de lisina
Produccin de cido
sulfhdrico
MIO
movimiento
Ornitina descarboxilasa
citrato
citrato
urea
urea
antibiograma
AM
AK
CF
CTX
CRO
CL
GE
NF
PEF
SXT
NET
PEF
CB
Colonia
blancas y
2- siembra
Negativo
negativo
positivo
positivo
negativo
negativo
negativo
negativo
variable
resistente
susceptible
susceptible
susceptible
susceptible
resistente
susceptible
susceptible
resistente
resistente
susceptible
susceptible
resistente
�Sal y manitol
EMB
Urocultivo
Agar sangre
Agar sangre
Mc conkey
Sal y manitol
Exudado
farngeo
Agar sangre
Mc conkey
Chocolate
Sal y manitol
Expectoracin
Agar sangre
Agar sangre
pequeas
Sin
crecimiento
Colonias
medianas y
opacas
Colonias
blancas y
pequeas
Sin
crecimiento
Colonias
blancas y
pequeas con
degradacin
de manitol
Colonias
blancas y
medianas
Sin
crecimiento
Colonias
pequeas y
blancas
Sin
crecimiento
Sin
Agar sangre
negativo
negativo
positivo
negativo
negativo
negativo
negativo
negativo
negativo
Agar sangre
negativo
negativo
�crecimiento
Sal y manitol
Chocolate
Sabouraud
McConkey
Colonias
blancas
grandes
con
hemolisis
y
beta
negativo
Sin
crecimiento
Sin
crecimiento
Colonias
blancas y
medianas
Sin
crecimiento
Mc conkey
Agar sangre
negativo
Sin crecimiento
Agar Chocolate
Colonias
medianas
blancas
Sal y Manitol
y
Sabureau
Colonias blancas y
medianas
degradacin
manitol
con
de
Sin crecimiento